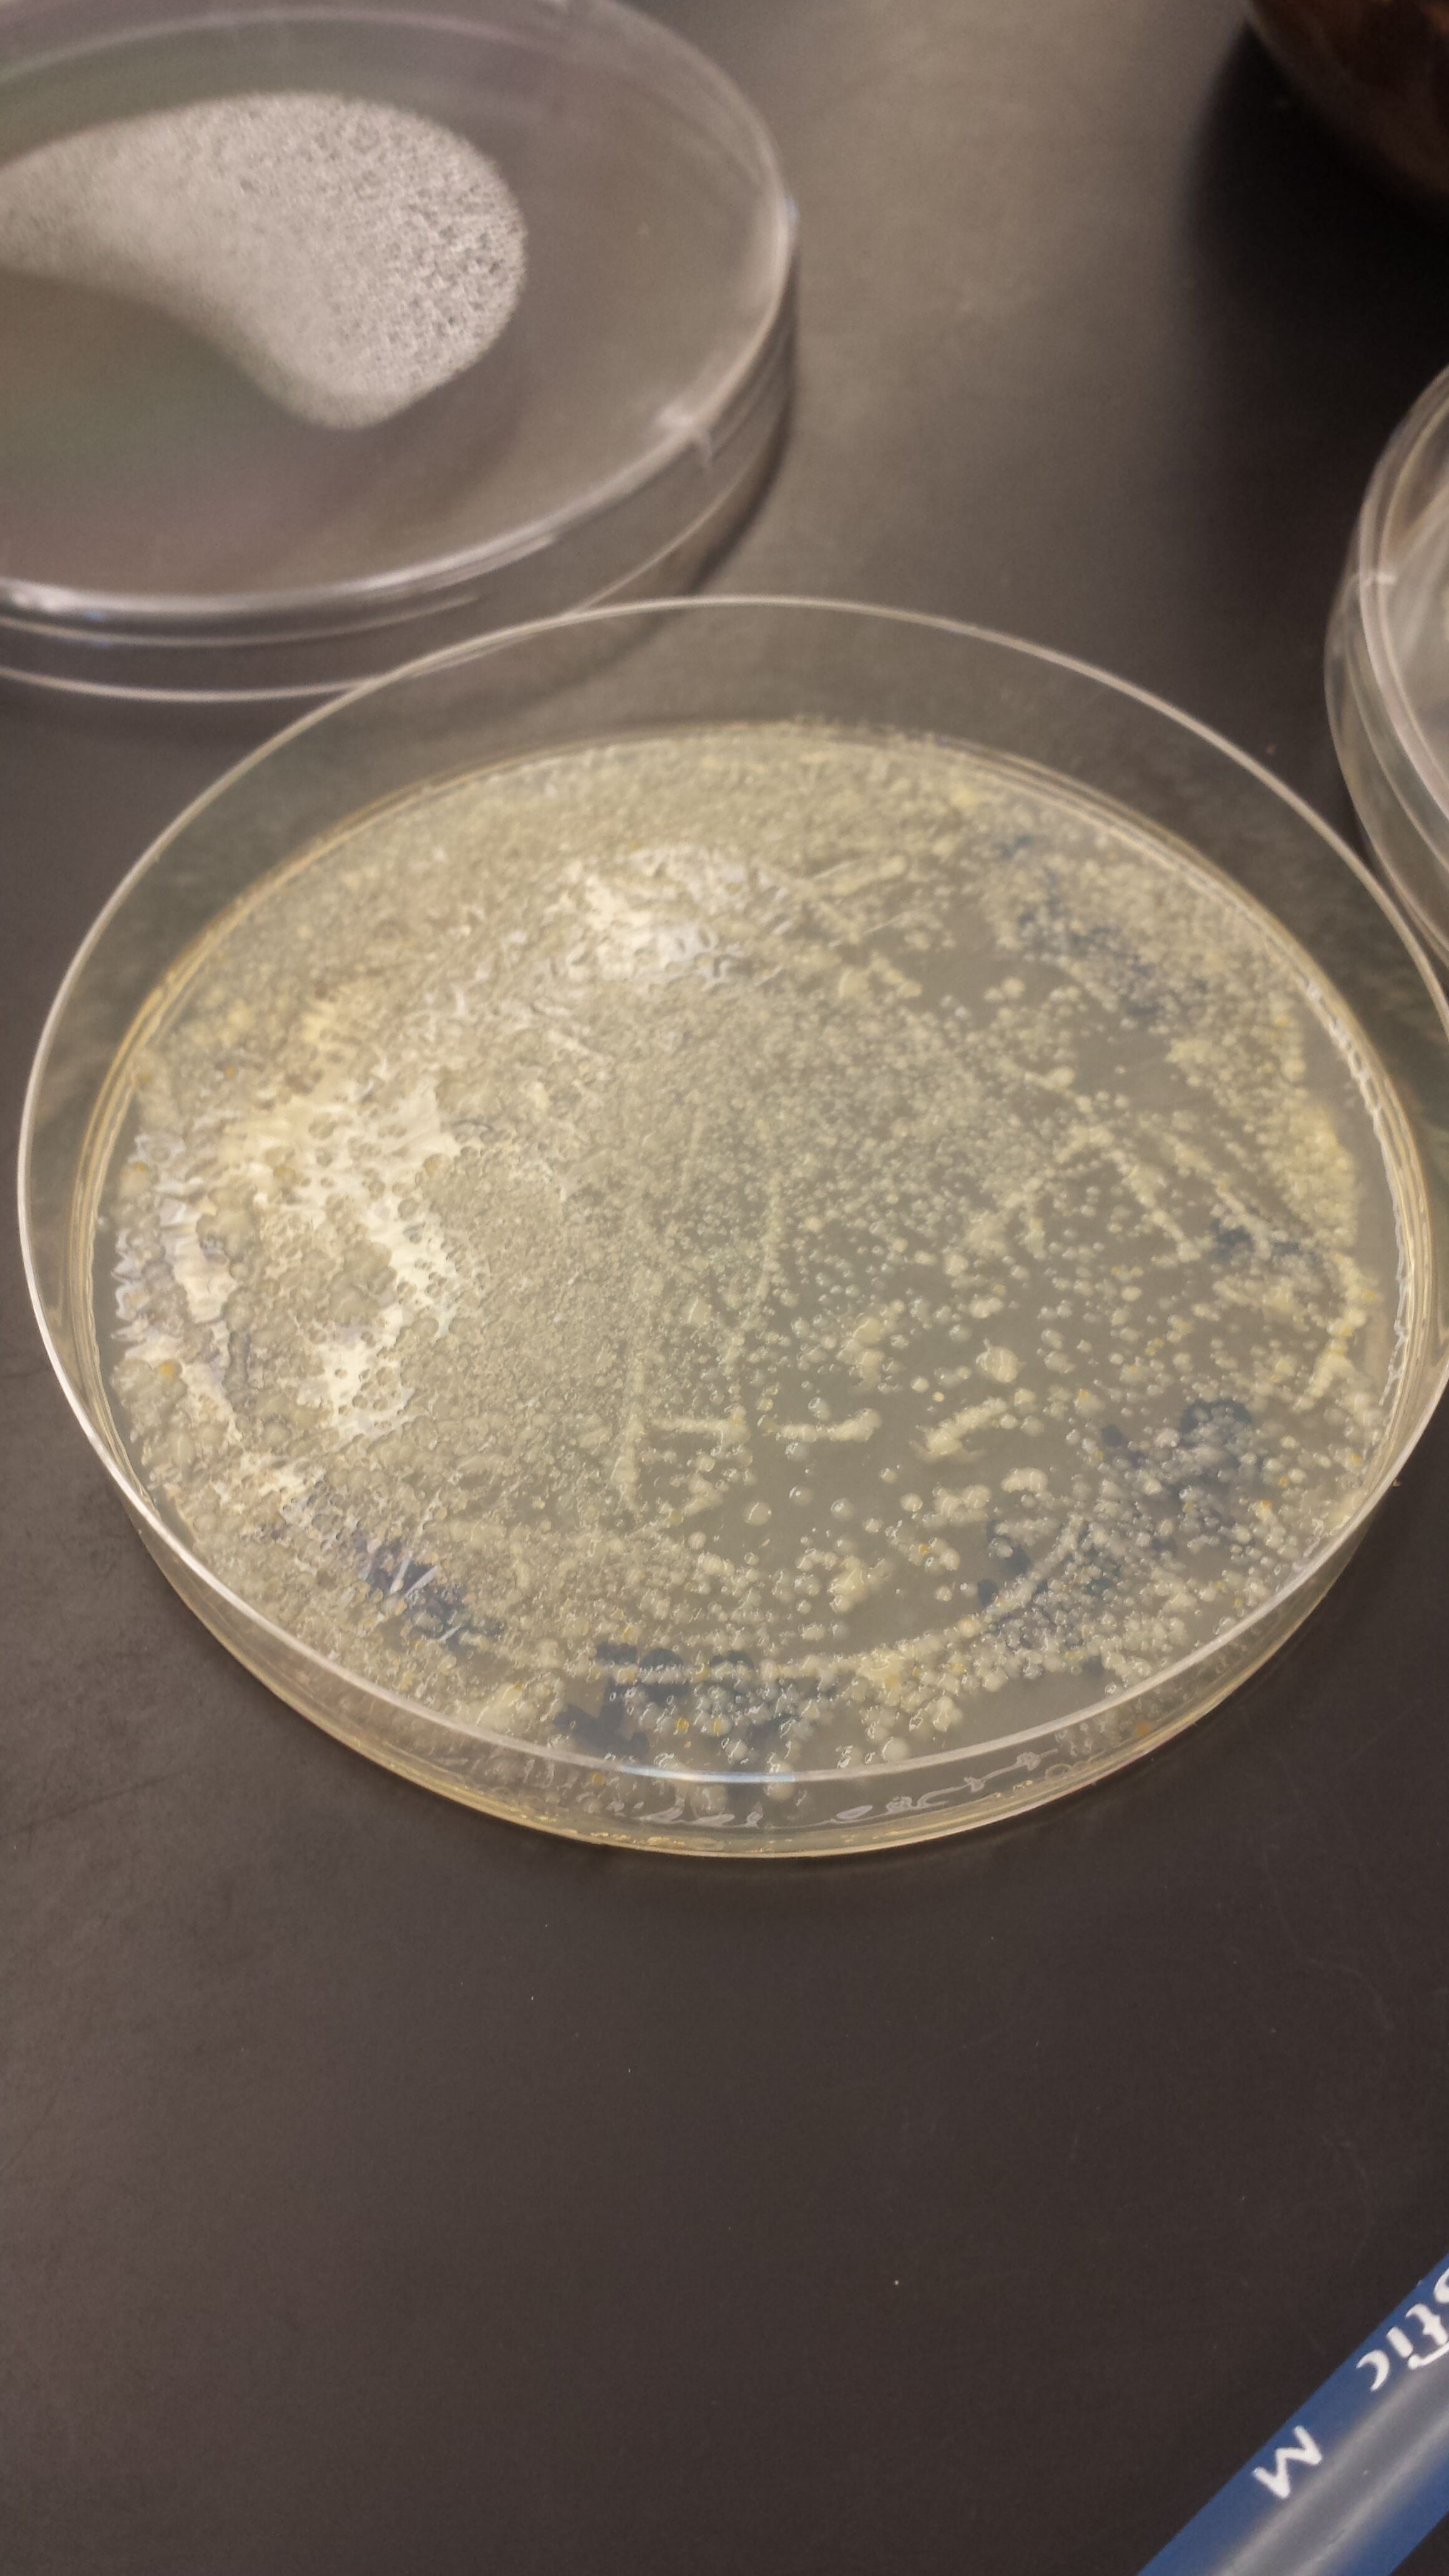
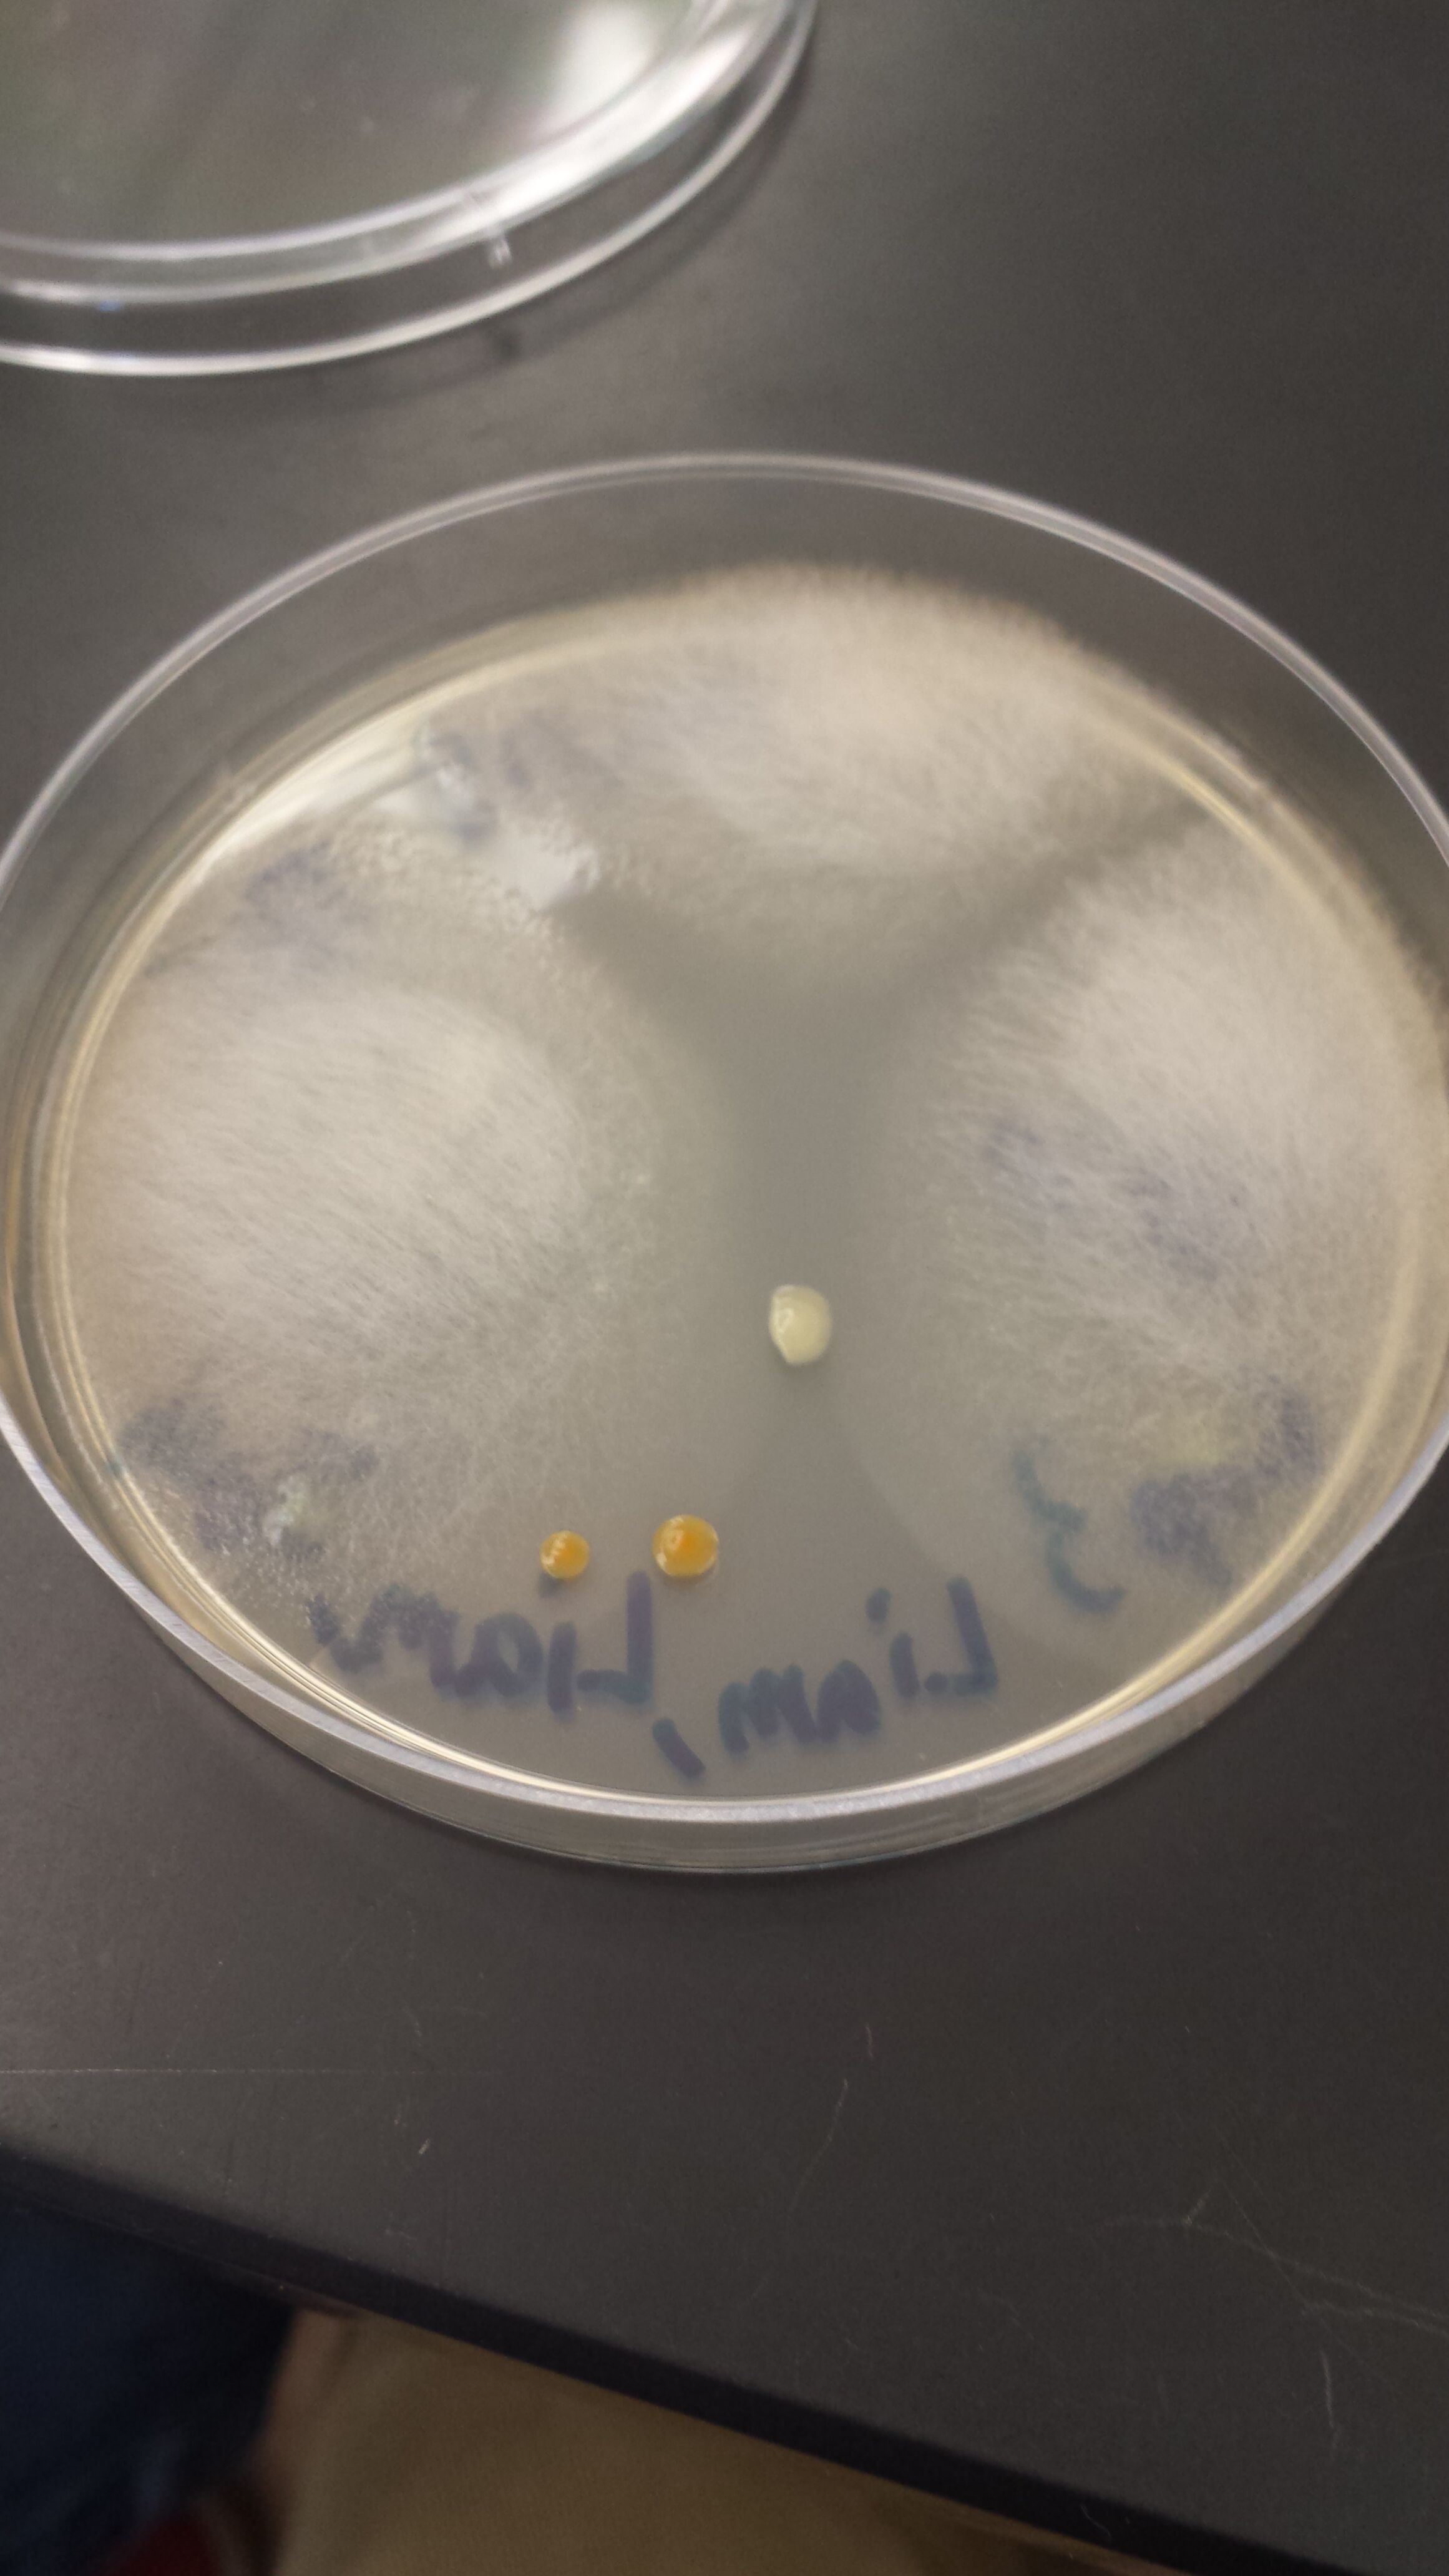
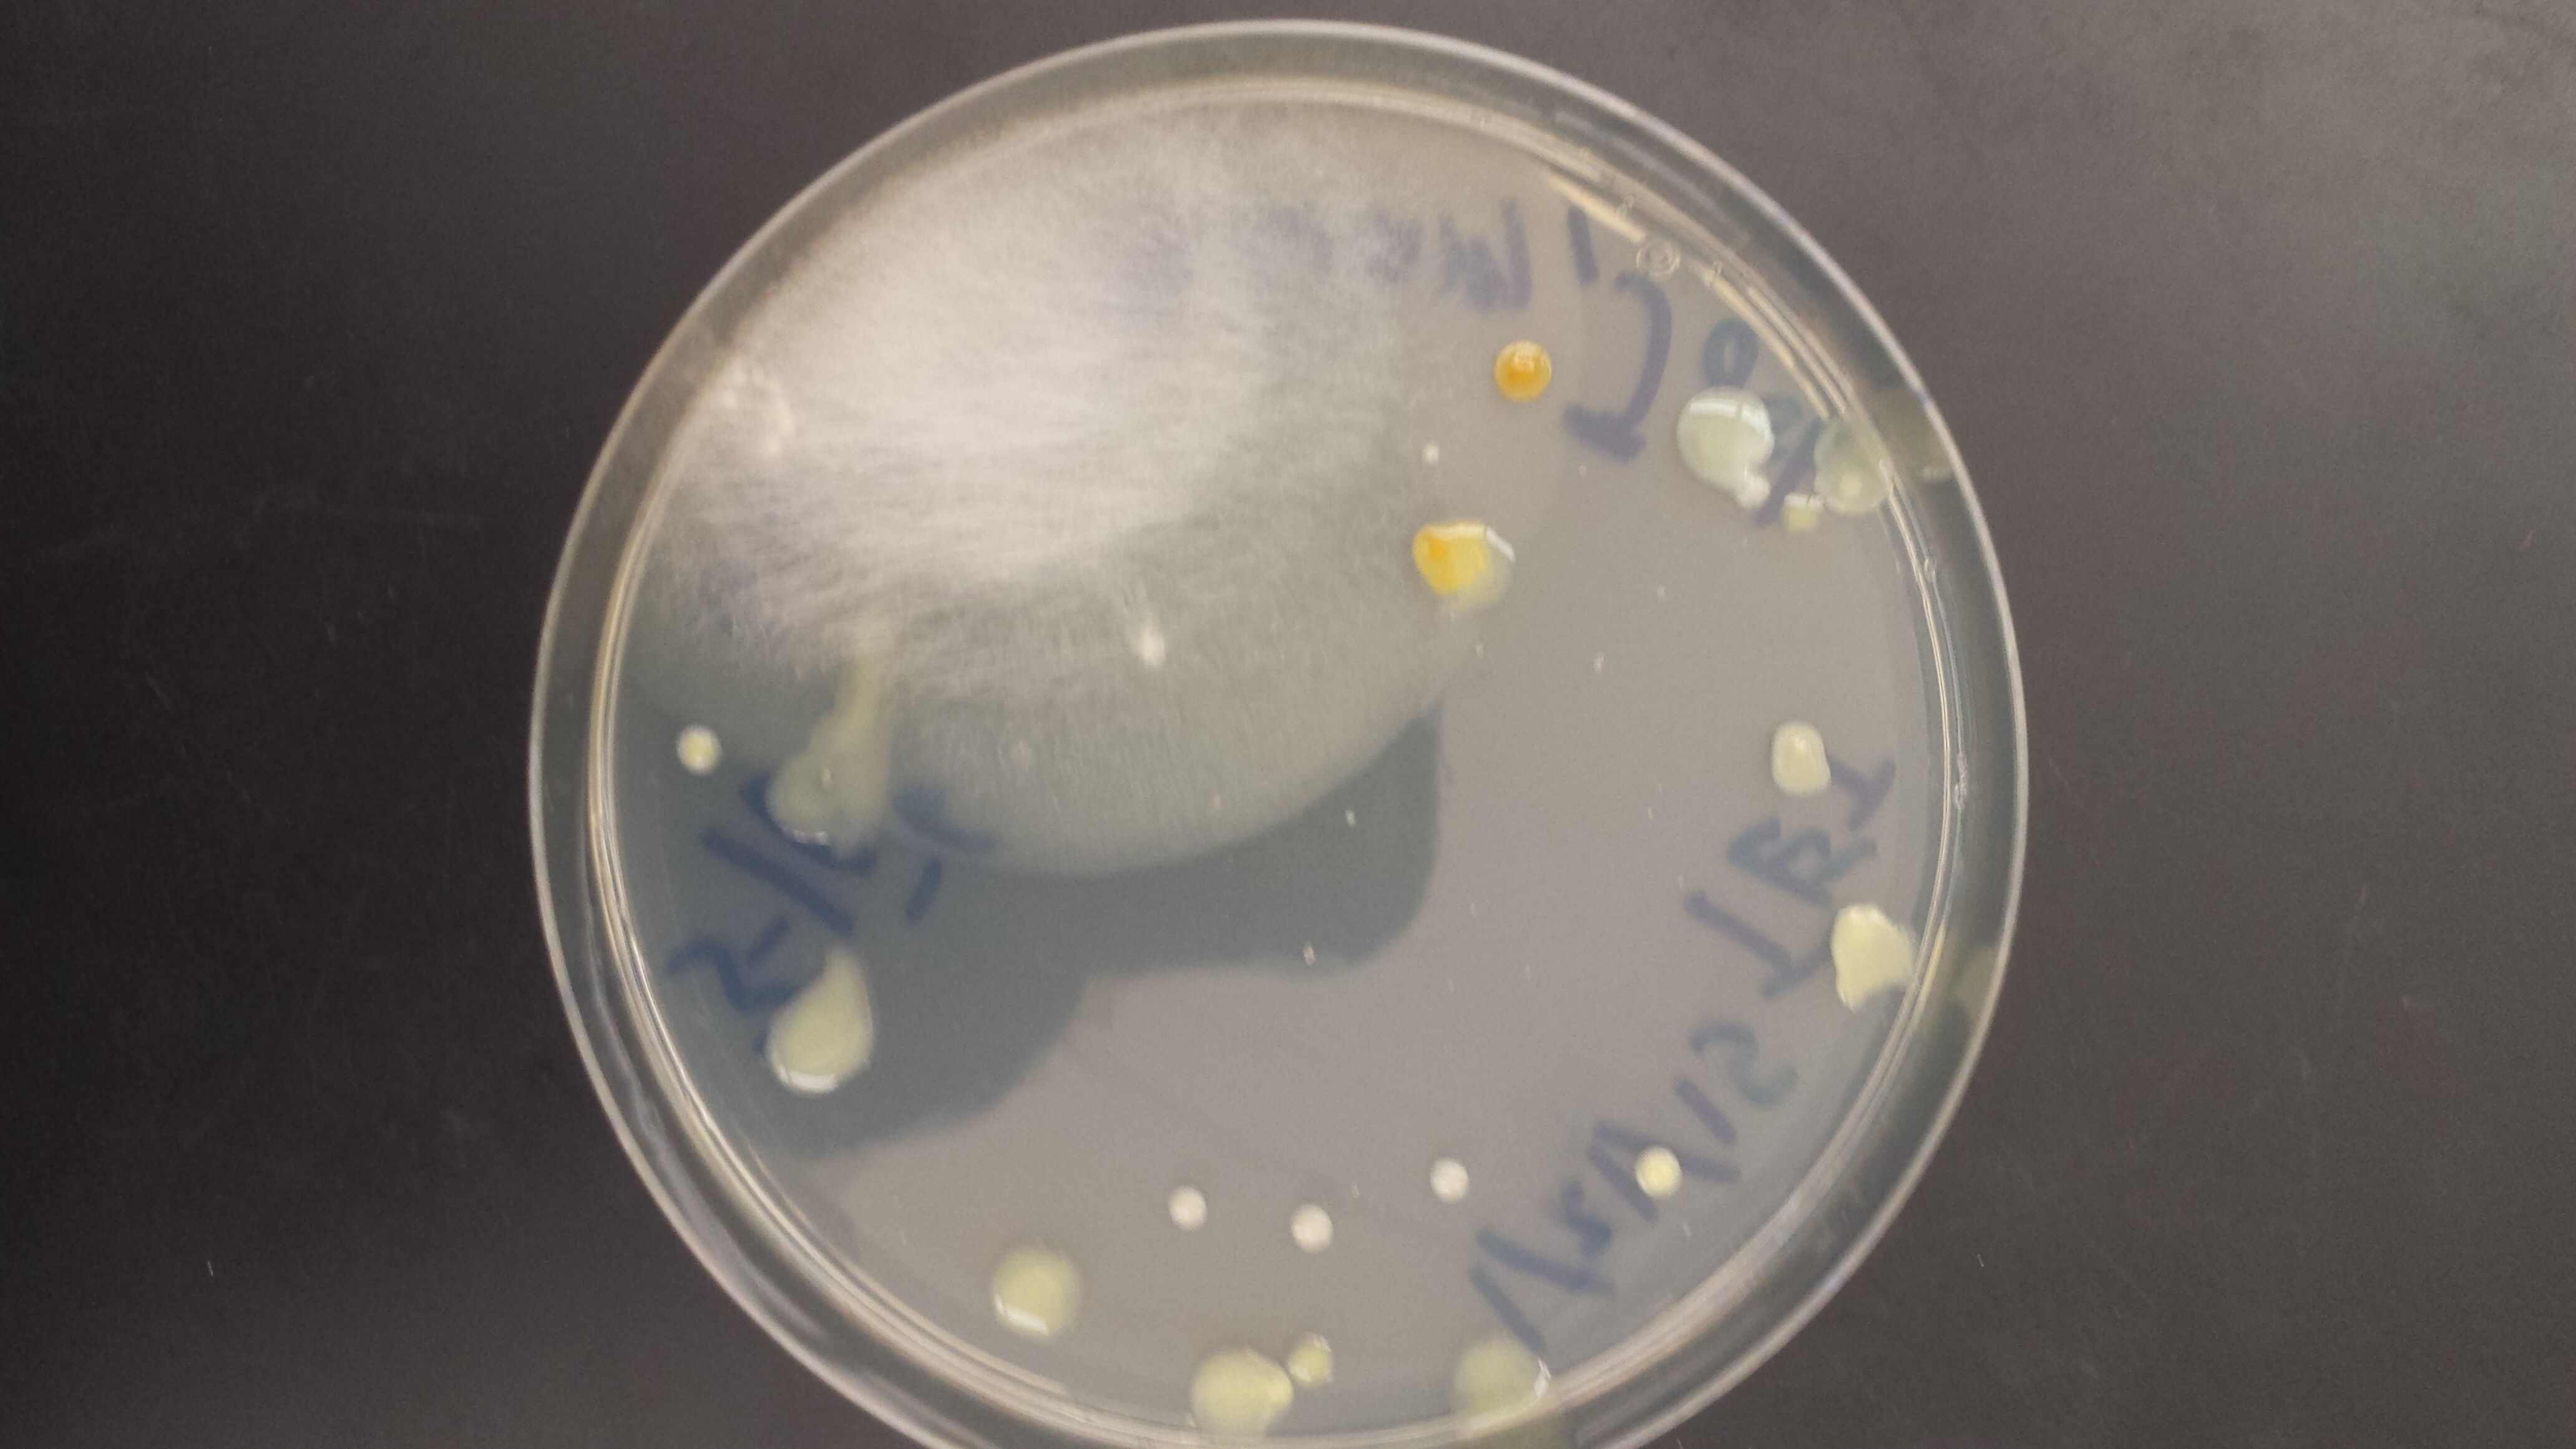
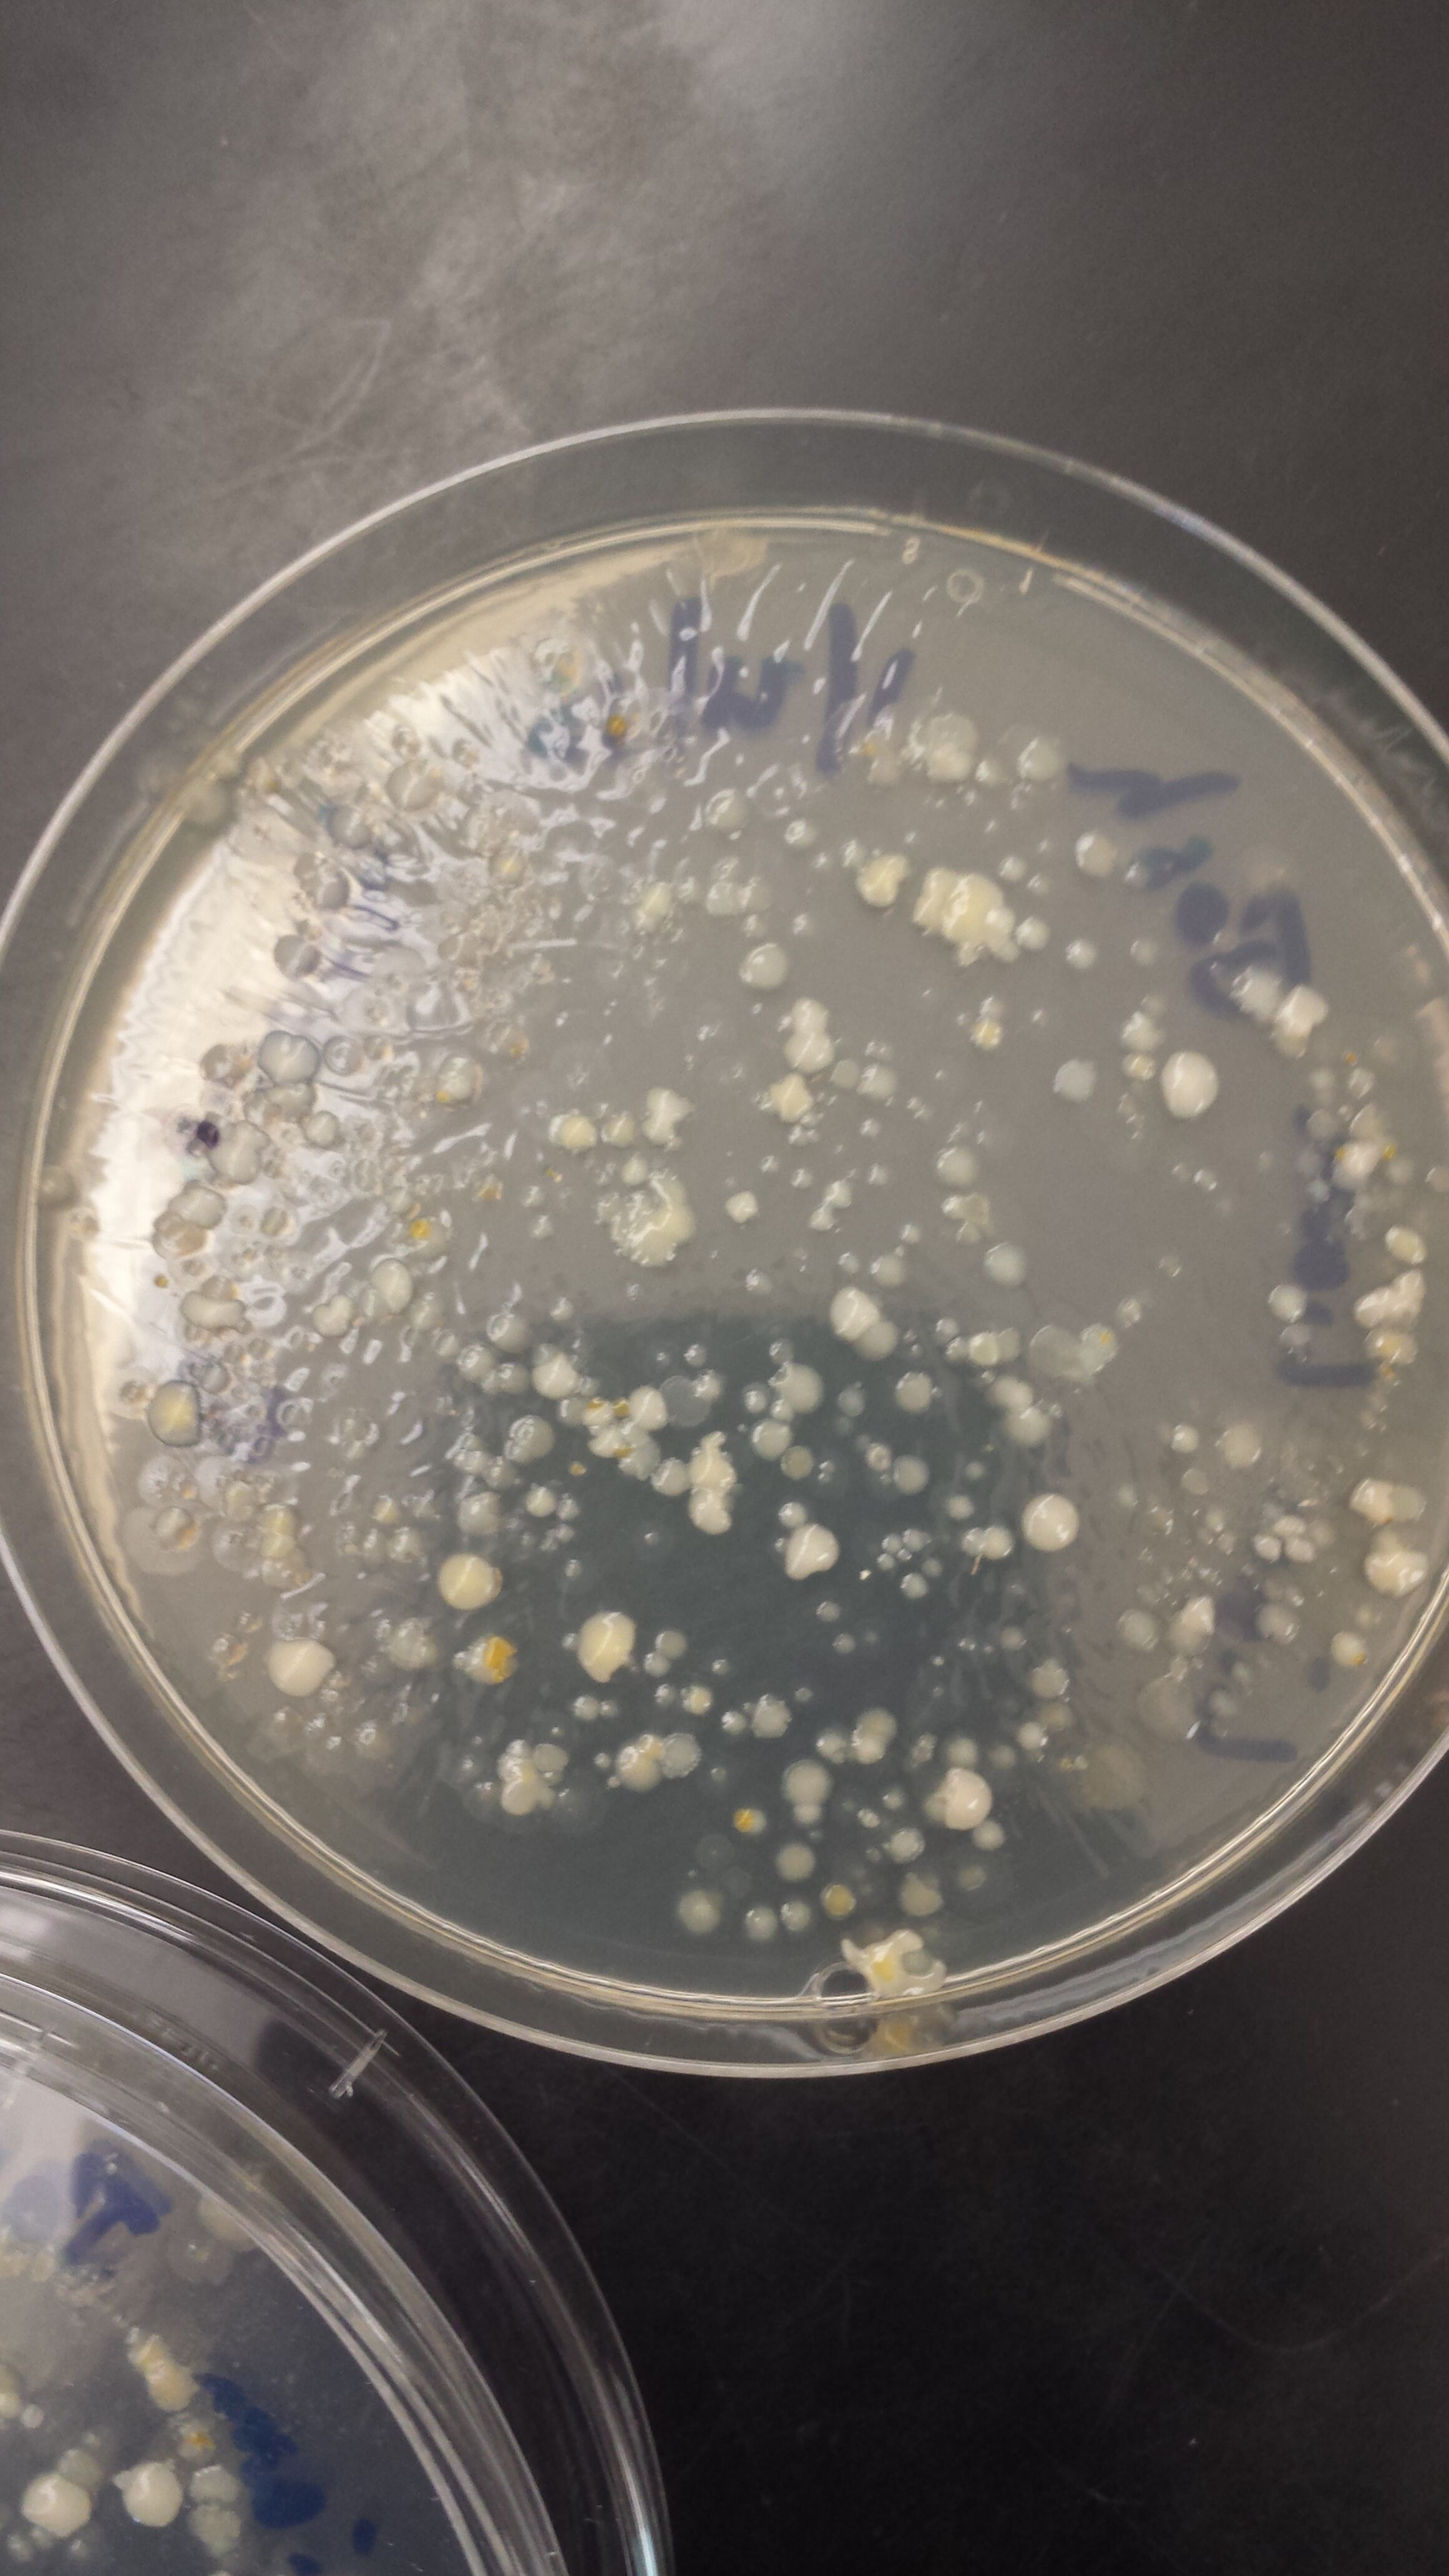

User:Joshua Terao/Notebook/Biology 210 at AU
February 25 2015
10^-3 Sequence: NNNNNNNNNNGNNGCNNNNNTGCAGTCGAACGGGGTANGCGTAANGCTGCTNCTAGAGGGGGAGAGGGGTGCGTGAGGGC NNAGCGTCTGACTGACCGCGGGAGAGGGGTTGAAANAGGAACGCTAAAACCATGAACGTCACAGAGGAAAAGGCGGGAGA CGGTGGCCTTTTGCTCTATTTAATGATNATGGGTGGGAGCCCGAGANGGTGGTGGTNNTCNCCGTAANGGNAAGATGTAT ATGGGGTCAGAGAANAAGCTNAGACNCAGAGAAACTGAGACAGCGTCCAGACTCATACGGGGGGNGGGTGTGGAATTTGG GGCAATGGGGGAAAGGGCCATATCCAGCCGTGCCGCGTGTGCGAAGAACGCCTGAGTTTTGCCCTGCTTTTTGTCTTGNG ATGAAGGCCAGGAATAAAATATTCTACNCTTGTGATTCTGACTGTACAAAAAGAATAAGGACCGGCTAACTCCGTGCCCG CAGCCGCGGTAATACGGAGGATGCTAGCGTTATTCAGATTTATTGGGTTTAACGCGTGCGTATGCGGTCTTTTAATTCAA TGGTCAAATACTCTACCTCAACTGTCGCATTGCCTTTGATACTGTAGTACTTGAGTCTGTTTGANGTGNGTGCAATTACA CGTGTAACGGTGATATNCATANATATGTCNNGGANCTCCNATTGCGNNNGCCTCTCCCTANNCTNNCACTGACGCTNATG CACGAANGNNNNNGGATCGAACAGGATTACATACNCTCNNNNNCCACNCCCTANACAATTATAACTTGATGTTTGNNAAG ACAAAANNCTNCCCNCCCNCCCCAANCNTTTNNTTNNTNNNCCTNNGGAGGAGGNNCNCCCNGGTGAANACTCNNNNGNN TTTNNNNNCNGNCNNCACNCNCNCANNANNNGNNNNNNNNNNNNNNTNATACNNNAANNAACCNTGCNNCCCCTCCTTNN NNNNNGGGGGNNGNGGANAANNANNNNNNNNNNGNTNNNNNNNNNNANGANGNAANNNNNNNNNGGNGGGGNNNNNNNNN NNNNNNNTNTTNNTANNNNNANNNGGNGNNNNNANCNNCNNNNNGTNNNNN
10^-3 tet Sequence: NNNNNNNNNCNTANNNTGCAGTCGTANCAANGTAGCCNNNNNNTCCTGGCGGCGAGTGGCGAACGGGTGAGTAATACATC GGAACGTGCCCAATCGTGGGGGATAACGCAGCGAAAGCTGTGCTAATACCGCATACGATCTACGGATGAAAGCAGGGGAT CGCAAGACCTTGCGCGAATGGAGCGGCCGATGGCAGATTAGGTAGTTGGTGAGGTAAAGGCTCACCAAGCCTTCGATCTG TAGCTGGTCTGAGAGGACGACCAGCCACACTGGGACTGAGACACGGCCCAAACTCCTACGGGAGGCAGCAGTGGGGAATT TTGGACAATGGGCGAAAGCCTGATCCAGCCATGCCGCGTGCAGGATGAAGGCCTTCGGGTTGTAAACTGCTTTTGTACGG AACGAAACGGCCTTTTCTAATAAAGAGGGCTAATGACGGTACCGTAAGAATAAGCACCGGCTAACTACGTGCCAGCAGCC GCGGTAATACGTAGGGTGCAAGCGTTAATCGGAATTACTGGGCGTAAAGCGTGCGCAGGCGGTTATGTAAGACAGTTGTG AAATCCCCGGGCTCAACCTGGGAACTGCATCTGTGACTGCATAGCTAGAGTACGGTAGAGGGGGATGGAATTCCGCGTGT AGCAGTGAAATGCGTAGATATGCGGAGGAACACCGATGGCGAAGGCAATCCCCTGGACCTGTACTGACGCTCATGCACGA AAGCGTGGGGAGCAAACAGGATTAGATACCCTGGTAGTCCACGCCCTAAACGATGTCAACTGGTTGTTGGGTCTTCACTG ACTCANTAACNAAGCTAACGCGTGAAGTTGACCGCCTGGGGAGTACGGCCGCAAGGTTGAAACTCAAGGAATTGACGGGG ACCCGCACNAACGGTGGATGATGTGGTTTAATTCNATGCAACNCNAAAAACCTTACCCACCTTTGACATGTACGGAATTC NNCAGANNTNGCTTANGGCTCNAANNANAACCGTTACACNGNTGCTGCATGGNNGTCNTCAGCTCGTGTCNNGAGNNNNT NGGGNTAANTCCCGNAACNAGCNCNNACCCNNTGNNN
The 10^-3 sequence was identified to be an uncultured bacterium. This means that the bacteria was unidentifiable. This is most likely due to the a mistake during the PCR process that would return poor results.
The 10^-3 tet sequence was identified to be the bacteria variovorex paradoxus. This bacteria does not match the description of what we found. Variovorax paradoxus is gram negative, while what we found is gram positive. This again is most likely due to errors during the PCR process.
February 18,2015
Lab 5: Invertebrates
The objectives of the lab are to first understand the importance of Invertebrates and second to learn how simple systems evolved into more complex systems.
The purpose of the lab is to familiarize ourselves with invertebrates, their methods of movements and their organ systems. We will also be learning how to identify the phyla of invertebrates. We will once again use the dichotomous key to identify the organisms we captured from the leaf in our transect.
Methods and materials (Procedures)
Procedure 1: Acoelomates, Pseudocoelomates, and Coelomates
We observed the acoelomate with the dissecting microscope. We saw that the movement of the Planaria was a stretch and shrink motion which glides the invertebrate through water.
We observed the nematodes and a cross sectional slide of their pseudocoelomate structure. Their movement consisted of a small, tight spiral motion to propel the invertebrate through the water.
We observed the coelomate Anelida, which has a body structure that is round. The movement of the invertebrates is a back and forth motion due to the round nature of its body.
Procedure 2: Anthropods
An arthropod is an invertebrate animal which contains an exoskeleton, a segmented body, and jointed appendages. The classifications of invertebrate phylum are crustacea, insecta, arachnida, chilopoda, and dilopoda.
Crustacea- these invertebrates are mostly aquatic and are all considered marine.
Insecta- these invertebrate have three body parts (head, thorax, abdomen). They have six legs. One pair of antennae. May have wings
Arachnida- these invertebrates include spiders, mites, ticks, scorpians and other. There is no Antennae. Two body parts (cephlothorax and abdomen). Four pairs of legs
Chilopoda- these are centipedes. They consist of a head and trunk. One pair of legs per trunk segment.
Dilopoda- these are millipedes. one pair of antennae. Two pairs of legs per trunk. Body consist of head and trunk.
Procedure 3:
Procedure 4:
Discussion:
In this lab we learned about the different invertebrates that live in our Transect. we learn the differences between the certain classifications and again reviewed our skills with the dichotomous key. We have to define and describe the five classifications of Invertebrates. then from the berlese funnel we identified the species in our transect. This gave us an idea what certain organism lay between the soil and leaves. The invertebrates are just as big a part of the transect as the plants and animals.
I've finally figured it out.
January 26, 2015:
Lab 1: Biological Life at AU
In this lab the main objectives were to 1, understand how natural selection drives the evolution of different species and 2, to make careful observations about the characteristics of a niche.
The Purpose of this Lab was to familiarize ourselves with microorganisms and our transects. This would help our understanding of Evolution by observing the surrounding environment. We also gathered materials for the follow-up lab a week from now.
Methods and Materials: In the first procedure we examined microorganisms with our microscopes. We observed three organisms ranging from smallest to largest called:
• Chlamydomas
• Gonium
• Volvox
These organisms are in the Volvocine Line.
The Procedure for dealing with our transect was:
• Observe the 20 by 20 meter transect
• Know the number of the transect
• Use a sterile 50 ml conical tube for soil and vegetation
The Procedure for the Hay Infusion Culture:
• Place 10 to 12 grams of the soil/ground water into the jar
• Add 0.1 grams of dried milk
• Mix for 10 seconds
• Remove lid and place on the table
• Label jar well
Data and Observations:
[1]
[2]
[3]
Abiotic Factors:
• Lampost
• Sidewalk
• Snow/water
• Soil
• Rocks
• Sprinkler
Biotic Factors:
• Tall bushes
• Leaves
• Plants
• Trees
• Short bushes
• Woodchips
Conclusions and future predictions:
I believe that the abiotic factors and biotic factors of our transect might change in the coming weeks.
I think that the hay infusion jar will have many microorganism we can observe through the microscope.
Great descriptions and documentation of your transect. Connecting OWW to Facebook is a great way to link pictures. Very complete, good job. ML
January 27, 2015
Lab 2: Identifying Algae and Protists
Main Objectives:
1. To practice using dichotomous key to identify species of micro organisms
2. To understand the characteristics of Algae and Protists
3. To examine Algae and Protists from your transect.
The purpose of this lab helped us to learn how to identify the different species of microorganisms using the dichotomous key. We also learn the three main kingdoms of microorganisms. We used our on hay infusion mixture in which we used our microscope skills to identify. We then practiced introduce the microorganisms to the eight culture plates.
Methods and Materials:
Procedure 1:
We used about six different microscopes to examine six different types of microorganisms. Then the next step was to follow the steps of the dichotomous key to identify the species that was presented. This was used as practice to learn how the dichotomous key worked and how to follow the questions to identify the specific species.
Procedure 2:
We first were to find our jar of hay infusion and bring it to our table. Then each lab partner drew a small sample of water from the top, middle, and bottom of the jar. We then were to identify two species using the dichotomous key from our samples.
Procedure 3: Preparing and plating Serial Dilutions
1. We were to label 4 tubes of 10 mLs of sterile broth with 10^-2, 10^-4, 10^-6, and 10^-8.
2. Then obtain a micropippetor set at 100 microliters and tips.
3. Obtain 4 nutrient agar and 4 nutrient agar plus tetracycline plates, and label all accordingly.
4. Swirl the jar, then add 100ul from the culture to the 10^-2 tube.
5. Add 100ul from the 10^-2 to the 10^-4 tube, repeat for the next two tubes.
6. Pipette 100ul from the 10^-2 tube and add to 10^-3 plate, repeat for next three tubes.
7. Repeat procedure for the agar plates plus “tet”
8. Store at room temperature for next class
Data and Observations:
In procedure 1 I found out how to work with the dichotomous key, and use it to identify different species in real-time. In procedure 2we worked with our own hay infusion jar from last class. The smell of the contents within the jar was horrible; it smelt like a really bad fart. It also looked really gross with a lot of brown colors. When we withdrew the samples from the water we noticed that there was a difference in the species that lived near the plant material versus the open water. The microorganisms we identified were the Colpidium, Actinosphaerium, Chlamydomas, and Eudorina. I predict that if the culture grew for another two months that new species and the amount of species will rise significantly.
Conclusions and Futrue Predictions:
I believe that for our hay infusion culture, there will be an increase in the total number of species within the culture.
For the agar plates I believe that the plates with “tet” added will likely see the most growth with the bacteria and the plate that contains the lowest ratio of culture to broth will grow the most bacteria, plate 10^-3.
Good job with the Hay Infusion description, the information about how to identify the species of microorganisms, and the serial dilutions. Photos of your identified protists would be helpful, especially when you have to come back to this information for the final assignment. Great job so far with your notebook. ML
February 4, 2015
Lab 3: Microbiology and Identifying Bacteria with DNA Sequences
Objectives are to understand the characteristics of bacteria, observe antibiotic resistance, and understand how DNA sequences are used to identify species.
Purpose is to keep emphasizing the importance of microbiology and learn their characteristics and how to identify them. There are three basic shapes of bacteria and they are:
1. Bacillus-rod shaped
2. Coccus- is spherical
3. Spirillum- twisted spiral
Another way of identification of bacteria is through the Gram stain. Bacteria which are gram-positive have a thick peptidoglycan layer in their cell wall which allows the stain to retain on the bacteria showing a crystal violet color (blueish). The bacteria which are gram-negative have less peptidoglycan so the dye does not retain very well leaving a pink stain.
Pre-Lab Observations: I believe that there will be no Archaea species on the agar plate simply because the environment is not extreme enough and Archaea are extremophiles. The Hay Infusion Culture still looks dirt brown but the water level has decrease about an inch or two. It smells a bit like leaves.
Materials and Methods:
Procedure 1: Quantifying and the observing Microorganisms
In this procedure we were to obtain our 8 agar plates and observe the bacteria growth on each with regards to the dilution.
Dilution
10^-3
10^-5
10^-7
10^-9
10^-3
10^-5
10^-7
10^-9
Agar Type
Nutrient
Nutrient
Nutrient
Nutrient
Nutrient + tet
Nutrient + tet
Nutrient + tet
Nutrient + tet
Colonies Counted
3000
84
215
400
205
15
22
6
Conversion Factor
x10^3
x10^5
x10^7
x10^9
x10^3
x10^5
x10^7
x10^9
Colonies/mL
3,000,000
8,400,000
2,150,000,000
400,000,000,000
205,000
1,500,000
220,000,000
6,000,000,000
Procedure 2: Antibiotic Resistance
Yes there are more white colonies on the plates with just agar as the plates which included tet had a mixture of yellow and white. On most of the tet plates there was fungi. The effect of tetracycline is that it slowed the growth of bacteria and the total number of colonies wasn’t even close to those of the plates without tet. The white bacteria colonies are affected and the yellow bacteria aren’t as affected by tet.
Tetracycline is an antibiotic in which it is able to bind to the ribosomes of bacteria stopping the synthesis of proteins. The types of bacteria that are sensitive to Tetracycline are those who do not have resistance gene for tet and have weak ribosomal protection.
Procedure 3: Bacteria Cell Morphology Observations
Bacteria Characterization
Colony Label
10^-3
10^-5
10^-3
10^-5
Plate Type
nutrient
nutrient
Nutrient + tet
Nutrient + tet
Colony Description
Small, White, Circular
Circular, dark Brown spots.
Circular, transparent
Rob shaped, very thin, transparent
Gram + or
Gram -
-
-
+
-
This part of the lab was very hard to describe simply because we had such a hard time trying to focus on the bacteria and most times we could not find it.
Data and Observations:
In procedure 1 I feel the data we collected made sense according to the table. We found that for plates that contained tet there was an equal ratio of yellow and white colonies but the plates without tet are full of white colonies. For the plates that had higher dilutions the amount of colonies was significantly lower. The third procedure taught us a specific method on how to Gram stain bacteria. We went through all the processes and came out with our four slides with stained bacteria.
Conclusions:
This lab really helped our understanding of the kingdom of bacteria. We got to analyze the different shapes of bacteria and the process of stain bacteria. We also dealt with the growth of bacteria.
You have all the information, but having smaller pictures and better formatted tables may make final analysis easier. ML
February 10, 2015
Lab 4: Plantae and Fungi
In this lab the main objectives were: 1. To understand the characteristics and diversity of plants. 2. To appreciate the function and importance of fungi.
In this lab we went over the history of plants in time and their lineages. The order of plant development was first Non-vascular plants, second seedless plants, third Gymnosperms seed plants, and fourth Angiosperms seed plants. We discovered the difference in the plants and the evolutionary history that changed plant life.
The purpose of this lab is to familiarize ourselves with the different types of plant species. We also learned how to identify the plant species of our transect.
Materials and Methods:
Procedure 1: Collecting five plant samples from the transect
In this part of the lab we collected five samples of stems and leaves from different plants in the transect.

Procedure 2: Plant Vascularization
In this part of the lab we describe the plants from our transect. The vascularization of a plant reffers to the structure of the plant. The stem and trunk of plants species was a very important evolutionary step in the plantae kingdom. The earliest of the plant species were catergorized as Bryophytes which are mosses. These types of plants obtain water through rhizoids which are small like like projections that anchor the plants. Bryophytes obtain water from the environment and distribute it through a slow process of diffusion. The newest evolutionary addition to the plant species is the Angiosperm. In Angiosperms the stem supports the weight of he flower and leaves and also transports water throughout the plant. Inside the stem there are specific plant structure cells called xylem and phloem layers. These layer are specifically responsible for the transportation of water. The xylem is also called on for structural support.
Procedure 3: Presence of Specialized Structures
In this part of the lab we learned about the presence of structure in plant species. leaves are some of the most important organs of plants since they perform the photosynthesis process. The upper most part of the leaf would be the cuticle, which is the waxy thin layer of the leaf. Next is the upperepidermis layer which contain plants cell which form the structure of the leaf. Then the palisade mesophyll cells come in and their primary focus is photosynthesis. The next layer the spongy mesophyll does more or less the same as the palisade mesophyll cells except they are much more spaced out. the lower epidermas acts as another layer of structural support to the leaf. The stomata cells are placed on the underside of the leaf to aid in the exchange of gases.
Procedure 4: Mechanisms of Plant Reproduction
There are major differences in the process of reproduction for Bryophytes and Angiosperms. The most important part is the comparison of the different reproductive cycles of the plant, Gametophyte versus sporophytes. In bryophytes the gametophyte stages dominte the life cycle of the plant while th sporophytes stage is short. In Angiosperms the opposite happens. The sporophyte stage dominates while the gametophytes stage is relatively short. The Bryophytes must use water for fertilization where the sperm must swim forom the antheriduim to the archegonium to fertilize the egg. The process for Angiosperms are not dependant on water. The pollen or sperm created from the stamen must be inserted into the stigma and must fertilize the egg cell in the ovaries. In additon to the plant being fertilized by hapliod sperms and egg cells the plants can also be fertilized by dipliod gamates. In class we could not find any evidence of flowers or spores.
Procedure 5: Observing Fungi
Procedure 6: Setting up the Berlese Funnel to Collect Invertebrates
In this part of the lab we used a funnel, ringstand, tube, tape and screen paper. We put the leaf litter in the funnel to allow organisms to drop down into the tube for exmination.
Data and Observation:
Throughout this lab the information we learned about different types of plant species, thier structures, their reproductive methods, their vascularization and fungi Identification. We took 5 different plant species samples from our transect to identify and classify. We also learned to identify the flowers.
Conclusion:
In the conclusion of the lab we famirliarized ourselves with the different plant species and identification of them also.